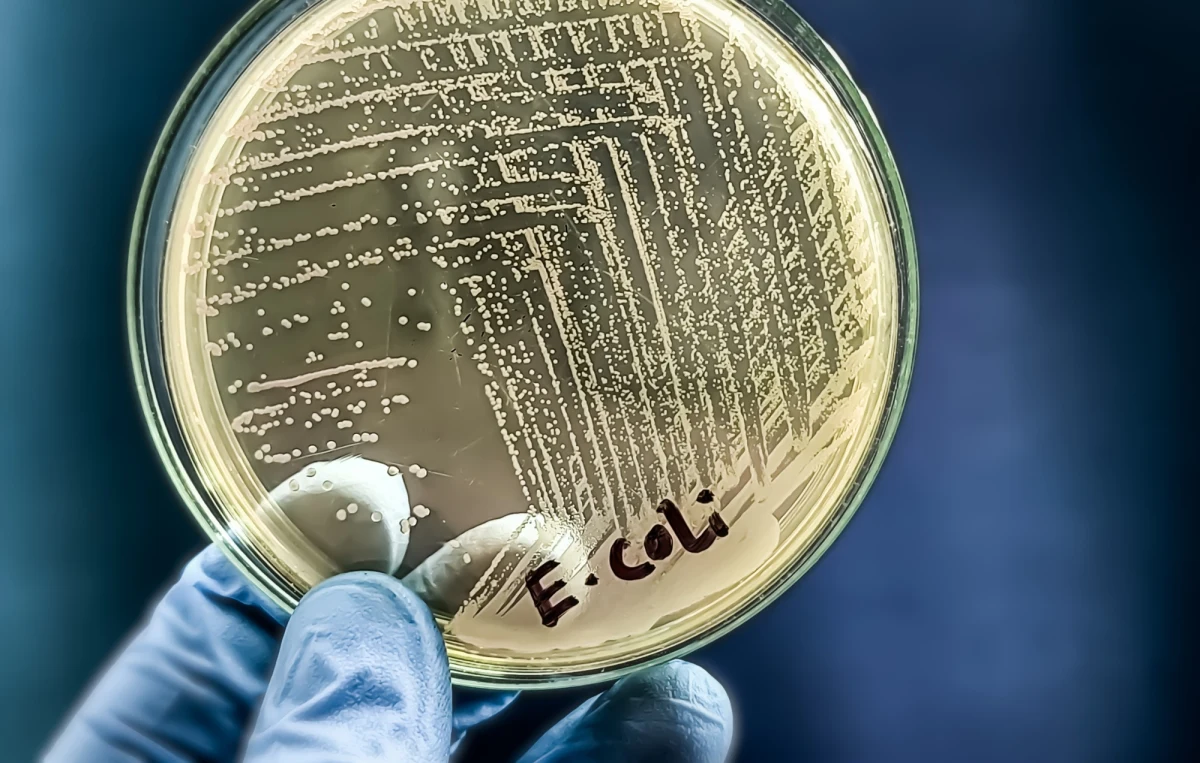
Woda w sześciu podwrocławskich miejscowościach nie nadaje się do spożycia. W wodociągu stwierdzono przekroczenie dopuszczalnych wartości liczby bakterii coli. Informację podał w środę wrocławski sanepid. To kolejny w ostatnich tygodniach taki przypadek na terenie Dolnego Śląska.

Woda w sześciu podwrocławskich miejscowościach nie nadaje się do spożycia. W wodociągu stwierdzono przekroczenie dopuszczalnych wartości liczby bakterii coli. Informację podał w środę wrocławski sanepid. To kolejny w ostatnich tygodniach taki przypadek na terenie Dolnego Śląska.
- Aktualne informacje z Polski i ze świata znajdziesz na stronie RMF24.pl.
Sanepid wykrył przekroczenie najwyższej dopuszczalnej wartości liczby bakterii z grupy coli w wodociągu sieciowym Święta Katarzyna. Zaopatruje on podwrocławskie miejscowości Święta Katarzyna, Grodziszów, Sulęcin, część Sulimowa, część Siechnic, Radwanice.
"Z uwagi na stwierdzone zanieczyszczenie woda nie nadaje się do użycia" - podano w środę w komunikacie Powiatowej Stacji Sanitarno-Epidemiologicznej we Wrocławiu.
Mieszkańcy miejscowości, do których dostarczana jest woda z wodociągu sieciowego Święta Katarzyna, nie powinni spożywać wody z kranu, ani używać jej do przygotowywania posiłków. Woda nie może być również wykorzystywana do mycia owoców, warzyw, naczyń kuchennych, prania. Nie nadaje się do mycia, kąpieli, mycia zębów i przemywania otwartych zranień.
Do mieszkańców tych podwrocławskich miejscowości Rządowe Centrum Bezpieczeństwa wysłało alert.